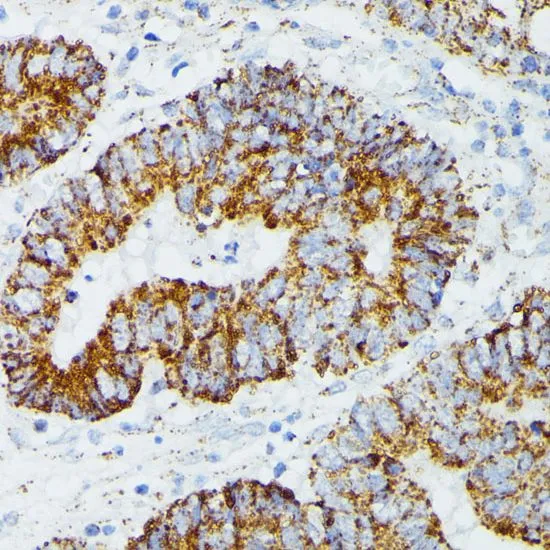

WB analysis of various sample lysates using GTX64809 ETHE1 antibody. Dilution : 1:1000 Loading : 25microg per lane
ETHE1 antibody
GTX64809
ApplicationsImmunoFluorescence, Western Blot, ImmunoCytoChemistry, ImmunoHistoChemistry, ImmunoHistoChemistry Paraffin
Product group Antibodies
ReactivityHuman, Mouse, Rat
TargetETHE1
Overview
- SupplierGeneTex
- Product NameETHE1 antibody
- Delivery Days Customer9
- Application Supplier NoteWB: 1:200 - 1:1000. ICC/IF: 1:50 - 1:200. IHC-P: 1:50 - 1:200. *Optimal dilutions/concentrations should be determined by the researcher.Not tested in other applications.
- ApplicationsImmunoFluorescence, Western Blot, ImmunoCytoChemistry, ImmunoHistoChemistry, ImmunoHistoChemistry Paraffin
- CertificationResearch Use Only
- ClonalityPolyclonal
- ConjugateUnconjugated
- Gene ID23474
- Target nameETHE1
- Target descriptionETHE1 persulfide dioxygenase
- Target synonymsHSCO, YF13H12, persulfide dioxygenase ETHE1, mitochondrial, ethylmalonic encephalopathy 1, hepatoma subtracted clone one protein, protein ETHE1, mitochondrial, sulfur dioxygenase ETHE1
- HostRabbit
- IsotypeIgG
- Protein IDO95571
- Protein NamePersulfide dioxygenase ETHE1, mitochondrial
- Scientific DescriptionThis gene encodes a member of the metallo beta-lactamase family of iron-containing proteins involved in the mitochondrial sulfide oxidation pathway. The encoded protein catalyzes the oxidation of a persulfide substrate to sulfite. Certain mutations in this gene cause ethylmalonic encephalopathy, an infantile metabolic disorder affecting the brain, gastrointestinal tract and peripheral vessels. Alternative splicing results in multiple transcript variants encoding different isoforms. [provided by RefSeq, Mar 2016]
- ReactivityHuman, Mouse, Rat
- Storage Instruction-20°C or -80°C,2°C to 8°C
- UNSPSC12352203